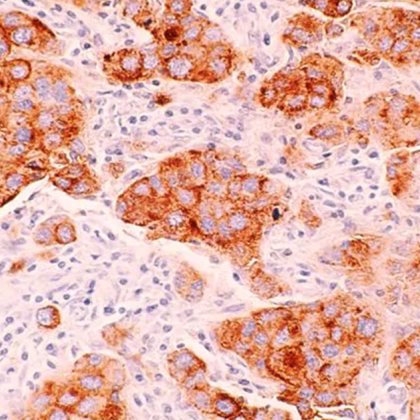
Скорошно проучване на учени от Mass General Brigham Clinic е

... Реалната полза за обществото е свързана с покриването на разходите от осигурителните структури. Генетичните изследвания остават ключов инструмент за избор на най-ефективната и щадяща терапия.
Химиотерапията - Новини
Революционен британски метод чете генетичния код на туморитеУчени от Лондонския
...... две трети от пациентите с рак на гърдата могат да преминат успешно лечение само с хормонална терапия, без да се подлагат на агресивните химически вливания.РЕКЛАМА
Обичаният комик сподели откровено за лечението си след претърпяна операцияОбичаният
...... че операцията не беше достатъчна и се наложи да мина и през химиотерапия, която ме извади извън строя" , написа артистът в личния си профил.РЕКЛАМА
Един от най обичаните български комици и сценични артисти Димитър Иванов Капитана
...... публикацията си Капитана разкри, че колегите му са му предложили да се включи в лятното турне на Кючуков и Донски.„Все още обмислям.“ - сподели той.
Контролираното намаляване на приема на калории може да увеличи ефективността
...... подчертават значението и на редовната физическа активност по време на химиотерапия, която може да намали страничните ефекти и да подобри качеството на живот на пациентите.
Изнервени пациенти чиито операции и жизненоважно лечение бяха отложени поради
...... Разгледайте повече Самолет се разбива с главата надолу на летището в Бангор, убивайки всичките шестима на борда - със смразяващо съобщение, чуто в последния момент
Учените откриха генетичните мишени на резистентността на рака и разработиха
...... точка в лечението на онкологията, която измества целите на лечението от палиативна помощ към устойчива ремисия чрез възстановяване на чувствителността на рака към стандартното лечение.
В деня на насрочена химиотерапия болен е бил принуден сам
...... елементарно нещо“.По последни данни на Евростат - българските пациенти продължават да доплащат най-много за здраве - над двойно повече от средното за Евросъюза, съобщи bTV.
В деня на насрочена химиотерапия болна жена е била принудена
...... последни данни на Евростат - българските пациенти продължават да доплащат най-много за здраве - над двойно повече от средното за Евросъюза. Снимката е илюстративна / Архив.
От години близка на тази жена която иска да остане
...... лечение на онкологични заболявания, както и необходимите консумативи, в това число "игли".Попитахме повторно касата дали покриват точно този консуматив - и все още очакваме отговор.
Четирима от всеки 10 пациенти с рак лекувани с химиотерапия
...... съсредоточат върху това как химиотерапията причинява конкретно нервната болка и върху разработването на терапии, които могат да защитят пациентите с рак, подложени на животоспасяващото лечение.
Четирима от всеки 10 пациенти с рак лекувани с химиотерапия
...... съсредоточат върху това как химиотерапията причинява конкретно нервната болка и върху разработването на терапии, които могат да защитят пациентите с рак, подложени на животоспасяващото лечение.
Принцът и принцесата на Уелс обновиха акаунтите си в социалните
...... роли в очарователните кадри Принц Луи изплези език, докато играе на люлка Катрин минава през папрат в момент на размисъл по време на кадрите
Принцесата на Уелс остави фина почит към крал Чарлз и
...... публични ангажимента през следващите месеци, когато мога.„Въпреки всичко, което се случи преди това , влизам в тази нова фаза на възстановяване с подновено чувство за
Кралските фенове хълцаха от радост докато изпращаха подкрепата си на
...... пътуване до Нова Зеландия ще бъде премахнато до намаляване на изискванията за пътуване, но програмата на Чарлз все още се очаква да бъде „доста пълна“
Трите деца на принцесата на Уелс играна наоколо засмяха буря
...... август Принцесата за първи път беше приета в болница през януари за това, което е било само Описан като планирана коремна хирургия. по-късно е открит
Катрин принцесата на Уелс каза че е завършила химиотерапията си
...... беше толкова смела да сподели битката си с рака и всички очакваме с нетърпение скоро да я видим да възобнови кралските си задължения“, каза Сунак.
Лондон Катрин принцесата на Уелс казва че е приключила
...... нейния тъст, британският крал Чарлз III. Разбира се, че принцесата ще се върне към лек график на задълженията и ще продължи да работи от дома.
Скорошно проучване на учени от Mass General Brigham Clinic е
...... в тази статия е чисто информативен и не съдържа медицински съвети. Ако имате здравословни проблеми, не забравяйте да се консултирате с лекар.Превод: GlasNews.bg / Снимка: Unsplash
Иън Уорд беше казано че ще умре след година – така
...... Разгледайте повече Пазете се от „синдрома на бабината чанта“ – педиатърът предупреждава за страховития начин, по който бабите и дядовците могат случайно да застрашат децата
Кейт Мидълтън определено е имала и по добри години от 2024
...... най-големите събития в календара на Кейт Мидълтън до край на годината е Денят на възпоминанието на 10 ноември, както и традиционният й коледен концерт в Уестминстърското абатство.
Кейт Мидълтън определено е имала и по добри години от 2024
...... най-големите събития в календара на до край на годината е Денят на възпоминанието на 10 ноември, както и традиционният й коледен концерт в Уестминстърското абатство.
Принц Уилям каза че съпругата му принцесата на Уелс Катрин
...... за въздуха, водата и дивата природа на планетата. Петима победители получават по 1 милион британски лири (1,3 милиона щатски долара) за осъществяване на своите проекти.
Принц Уилям каза че съпругата му принцесата на Уелс Катрин
...... за въздуха, водата и дивата природа на планетата. Петима победители получават по 1 милион британски лири (1,3 милиона щатски долара) за осъществяване на своите проекти.
Принцесата на Уелс Кейт Мидълтън се появи неочаквано заедно със
...... Мидълтън говори за "добри и лоши дни", а дворецът Кенсингтън предупреди, че организацията трябва да бъде гъвкава като може да се наложат промени в последния момент.
Кейт принцесата на Уелс се появи неочаквано заедно с принц
...... Вие можете да допринесете за нашия стремеж към истината, неприкривана от финансови зависимости. Можете да помогнете единственият поръчител на съдържание да сте вие – читателите.
Принцесата на Уелс Кейт Мидълтън се появи неочаквано заедно със
...... и служителите на спешната помощ, описани от принц Уилям като „герои“. След като химиотерапията ѝ приключи, принцесата на Уелс започна постепенно да се връща към работата си.
Неочакваното появяване на принцесата на Уелс Кейт заедно със съпруга
...... като напомняне за значителното влияние, което членовете на британското кралско семейство могат да окажат върху живота на хората, предлагайки утеха и солидарност в трудни моменти.
Кейт Мидълтън официално се завърна към кралските си задължения след
...... прекараха известно време и с учителката по танци, която бе сериозно ранена по време на атаката, докато се опитваше да предпази децата от нападателя им.
Кейт принцесата на Уелс се появи неочаквано заедно с принца
...... тя пристигна със съпруга си, за да се срещне със семействата на опечалените и със спасителите, които принц Уилям определи като "герои“. — Prie
Кейт принцесата на Уелс се появи неочаквано заедно с принца
...... семействата на опечалените и със спасителите, които принц Уилям определи като "герои".След като химиотерапията ѝ приключи, Кейт започна постепенно да се връща към активна дейност.
Принцесата на Уелс Кейт на първа публична проява след приключването
...... оръжие на 29 юли, по време на урок по танци, предава БНТ. 17-годишният извършител беше задържан. Трагедията беше последвана от масови протести и бунтове на Острова.
Принцесата на Уелс Кейт на първа публична проява след приключването
...... беше задържан. Трагедията беше последвана от масови протести и бунтове на Острова.Последвайте ни във и Вече може да ни гледате и в Намерете ни в
Принцесата на Уелс Кейт Мидълтън се появи неочаквано заедно със
...... семейства и служителите на спешната помощ, описани от принц Уилям като „герои“.След като химиотерапията ѝ приключи, принцесата на Уелс започна постепенно да се връща към работата си. FaceBookTwitterPinterest
Кейт принцесата на Уелс направи първата си публична поява в
...... ден на краля през юни, известен като Trooping the Colour, и наскоро по време на мъжкия финал на Уимбълдън през юли, където получи бурни овации.
Гореща новина за първата дама на Острова Кейт Мидълтън принцесата на
...... краля през юни, известен като Trooping the Colour, и наскоро по време на мъжкия финал на Уимбълдън през юли, където получи бурни овации, отбелязва БТА.
Кейт принцесата на Уелс направи първата си публична поява в
...... ден на краля през юни, известен като Trooping the Colour, и наскоро по време на мъжкия финал на Уимбълдън през юли, където получи бурни овации.
Кейт Мидълтън направи първата си публична поява след като обяви края на
...... за простите, но важни неща в живота, които толкова много от нас често приемат за дадено. Просто да обичаш и да бъдеш обичан.", заяви Кейт.
Кейт принцесата на Уелс направи първата си публична поява в
...... ден на краля през юни, известен като Trooping the Colour, и наскоро по време на мъжкия финал на Уимбълдън през юли, където получи бурни овации.
42 годишната принцеса Катрин от Уелс посети църквата Крати Кърк в
...... направя всичко възможно, за да остана без рак“.Според принцесата, тя продължава лечението и има още много работа, преди да може да се нарече напълно здрава.
Кейт Мидълтън Кейт Мидълтън е родена на 9 януари 1982
...... краля през юни, известен като Trooping the Colour, и наскоро по време на мъжкия финал на Уимбълдън през юли, където получи бурни овации, отбелязва БТА.
Принцесата на Уелс проведе първата си среща в замъка Уиндзор
...... и като поеме някои ангажименти. Очаква се тя да се присъедини към членовете на кралското семейство в кенотафа през ноември за възпоменалната неделя. автор: СЛАВА...
Миналата седмица принцесата на Уелс потвърди че е приключила лечението
...... "потенциално“ се очаква Кейт да присъства, е неделната служба за възпоменанието в подкрепа на кралското семейство, ветераните и техните семейства на 10 ноември, пише Ladyzone.bg.
На 10 септември по време на първото кралско събитие принц Уилям сподели че
...... път към пълното й възстановяване, принцесата на Уелс доказва, че дори в най-тежките моменти, силата на духа и любовта на семейството могат да направят чудеса.
Катрин принцесата на Уелс обяви че е приключила лечението си
...... York Times. Във видеообръщение тя сподели: „С наближаването на края на лятото не мога да опиша облекчението, което чувствам, след като най-накрая приключих химиотерапията.“
Съпругата на принц Уилям предприе безпрецедентна стъпка за да съобщи
...... Тя не планира да придружава принц Уилям на наградата Earthshot в Кейптаун през ноември, тъй като ще остане в Обединеното кралство с децата си. Автор:Космо ру
Съпругата на принц Уилям предприе безпрецедентна стъпка за да съобщи
...... Тя не планира да придружава принц Уилям на наградата Earthshot в Кейптаун през ноември, тъй като ще остане в Обединеното кралство с децата си. Автор:Космо ру




)





)